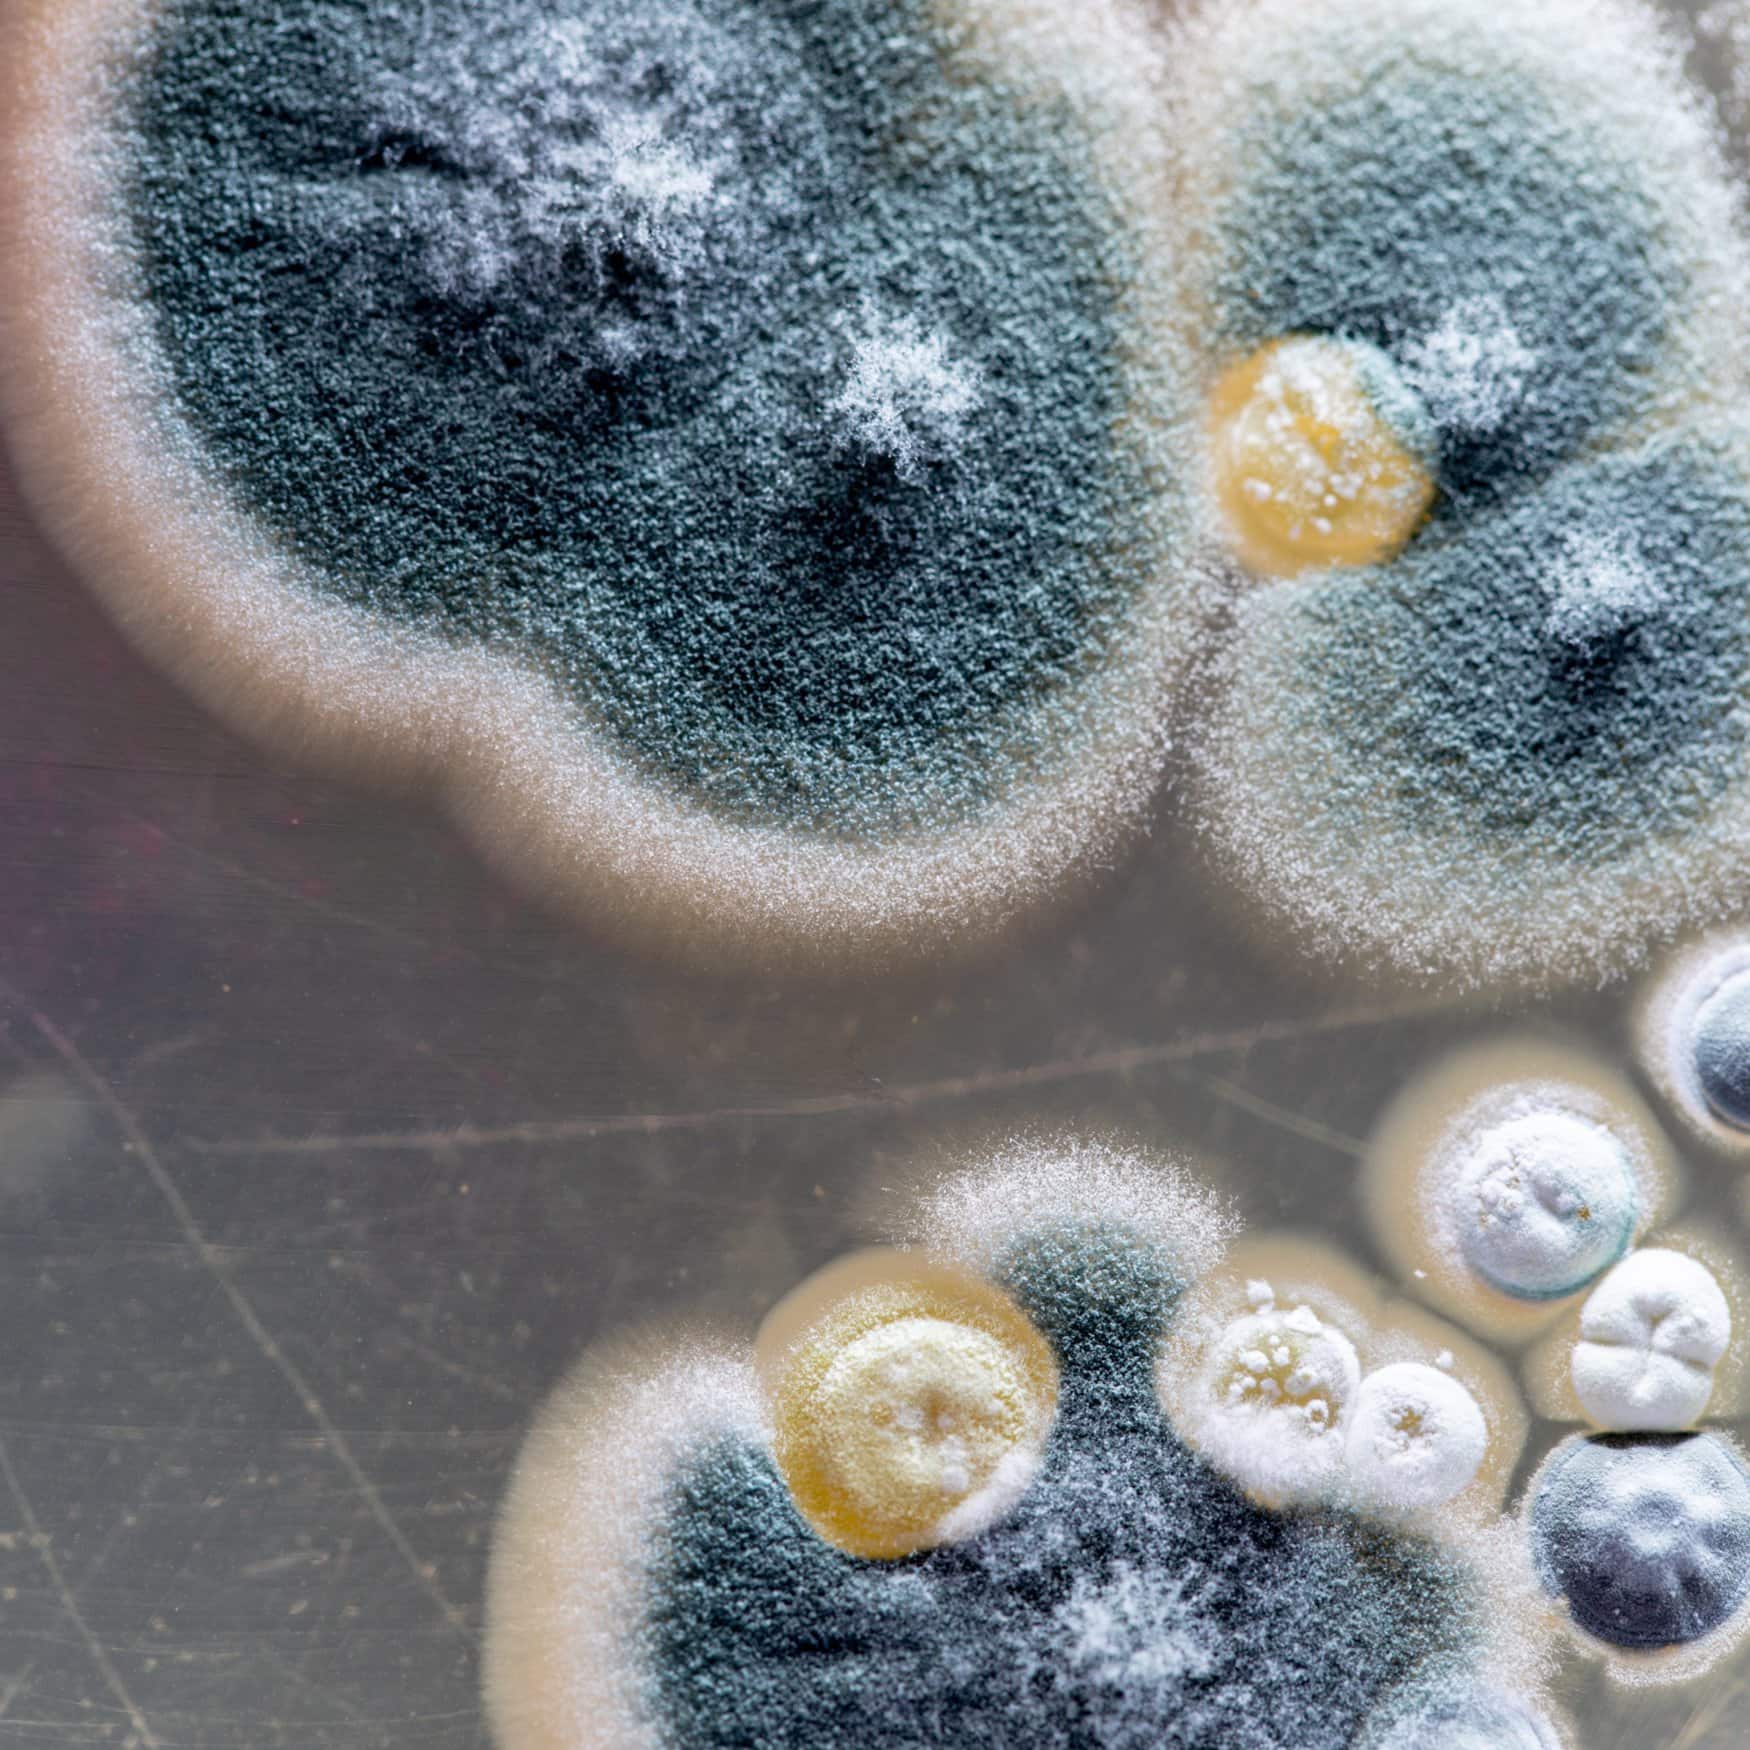

Тема: высокие технологии в сельском хозяйстве
Связанные темы
Следите за этой и другими темами прямо из своей почтовой программы на компьютере или смартфоне.
Котировки акций
Популярные материалы
Конференции
Прямой эфир
Анастасия
5 сентября, 11:25
Любопытная практика Уралхим - присваивать результаты чужого труда. Напоминаю Fertilizer Daily и Уралхиму, что использование изображений без разрешения является нарушением авторских прав. Просьба связаться со мной для урегулирования данного вопроса в досудебном порядке.
«Уралхим» стал участником конференции «Разнотоннажная химия 2025»